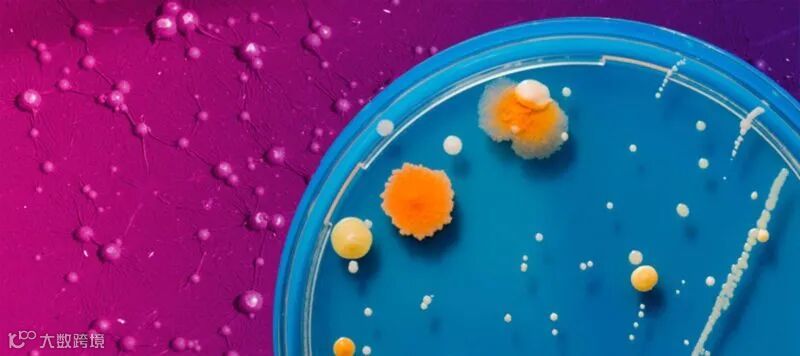

高通量筛选软件
虽然从一开始就在发霉的食物上观察到了微生物菌落,但直至1887年微生物学家Julius Richard Petri 发明了皮氏培养皿才真正推动了细菌菌落形态的研究。然而,菌落形态的定义是什么?在这里,我们将讨论这个问题以及如何识别不同菌落形态的问题。
菌落形态的简明定义
细菌(或真菌)菌落形态是指菌落在琼脂平板上的外观。观察和描述细菌菌落的形态是微生物学家研究过程的核心部分。由于不同类型的细菌具有不同的特征,因此进行菌落形态的观察通常对微生物学家的技能发展或通常在实验室处理细菌的任何研究人员都至关重要。形态变量包括(但不限于)其大小(直径),与其他菌落的分离、椭圆度、颜色、是否形成光晕以及菌落周围轮廓的模糊度或锐度。
如何识别和描述不同的菌落形态
现在已经清楚了菌落形态的定义,那么如何识别它们呢?菌落通过详述以下不同特征进行区分。要识别一个群体,科学家只需将其外观与预先存在的数据或知识相匹配。
菌落形态
这是指菌落的整体形状,如圆形、不规则、丝状等。例如,金黄色葡萄球菌通常在琼脂平板上显示为完美的圆形菌落。
菌落高度
描述菌落形态的另一种方法是,从侧面观察时,将高度定义为菌落显示的形状。通常,海拔被描述为平坦、凸起、凸出、枕状、伞形和火山口状。
菌落边缘
这是指暴露在空气中的菌落边缘的结构。通常注意到的一些常见形态有全缘、波状、丝状、叶状、卷曲、扇形和锯齿状。炭疽杆菌形成的菌落是一种具有明显丝状边缘的菌落。
菌落大小
这是真菌和细菌菌落形态的一个重要特征。该度量通常以毫米为单位。然而,菌落的大小有时也用相对术语来描述,如点状、小型、中型或大型。
菌落生色/颜色
颜色是描述菌落形态的一种简单而精确的方法。菌落可以显示单一颜色,也可以从中间到外部显示不同的色调。需要注意的是,在琼脂平板上看到的颜色可能不是细菌的实际颜色,而是由于细菌浸泡在培养基中而产生的色素。然而,当结合菌落的其他描述特征时,产生的色素有助于识别。菌落,可以帮助识别鉴定。
当记下颜色时,同时记下观察到的菌落的不透明度。不透明度通常描述为透明、半透明、不透明或彩虹色。
菌落表面与一致性
观察菌落的表面和结构/一致性也有助于识别菌落;表面被描述为有光泽、无光泽、光滑、粗糙、纹理、发亮、起皱等。另一方面,通常在触摸或刮擦菌落后描述一致性或纹理。纹理描述的一些示例包括干燥、易碎、粘液、丁酸和粘性。
一旦观察和描述了菌落,微生物学家就可以利用他们的先验知识或参考文献轻松地识别它。如果要复制已识别的菌落,则可以进一步进行菌落挑取过程。
细菌菌落形态识别:一个重要的前期工作
菌落形态观察是鉴定和进一步利用培养菌落的重要前期步骤。希望这篇关于菌落形态的定义以及如何识别菌落的短篇文章能让你有所启发。为了在实验室有效识别和挑选菌落,我们推荐Hudson公司的RapidPick自动菌落挑选仪。

推荐阅读:
>>20针菌落挑选仪! 一心四用: 挑样,接种,清洗,消毒 无间断进行!
>>如何让流式细胞仪、RT-PCR系统或多功能酶标仪微孔板装载更简单?
>>MINI TALKS:5分钟全面了解如何选择合适的自动菌落挑选仪
>>DNA/RNA样本纯化如何确保所有样品孔都高效且同效率洗脱
>>Hudson Rapid_pH:助力pH检测的应用及其自动化
>>Hudson Micro10x:非接触式分液器是加快冠状病毒检测的理想工具!
>>Hudson Robotics:增加流式细胞仪COVID-19检测通量
>>Hudson Robotics:自动化COVID-19研究的核酸/蛋白提取纯化
>>Hudson Robotics:增加流式细胞仪COVID-19检测通量
>>挑菌原来可以这样简单方便!
>>Rapid_pH 自动pH检测仪——带温度补偿的pH计
>>小身材高通量菌落挑选仪,自动化so easy!
>>Hudson生物合成自动化方案
>>新品推荐:Hudson PlateCrane SciClops机械臂
>>高通量自动化pH定量新方案
>>新品推荐:Rapid_pH™ pH值自动测定仪
>>重磅推荐:Hudson RapidPick自动克隆菌落挑选仪
欢迎关注伯齐官方微信(微信公众号:Bio-Gene)
回复:hudson,查看相关视频
长按以下二维码可识别关注公众号

伯齐科技有限公司
Bio-Gene Technology Ltd.
广州伯齐生物科技有限公司
热线:176 2009 3784
www.bio-gene.com.cn
marketing@bio-gene.com.cn


